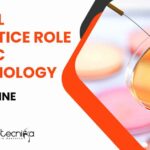
Piramal Apprentice Role For MSc Microbiology – Apply Online Piramal Apprentice MSc Microbiology
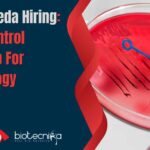
Zydus Takeda Hiring: Quality Control Officer Job For Microbiology – Apply Now! Zydus Takeda Hiring

Home Search
microbiology - search results
If you're not happy with the results, please do another search
Panacea Biotec Quality Assurance Job For Microbiology – Apply Now
Panacea Biotec QA Job For Microbiology - Apply Now
SCIENTIFIC OFFICER-STERILITY ASSURANCE (QA)
MANUFACTURING UNIT, Baddi, Himachal Pradesh, India
Department: SAG QUALITY ASSURANCE
Job posted on: Jun 24,...
AIIMS Jodhpur Non-Med Project Scientist Job Opening For Biotech, Biochem & Microbiology
AIIMS Jodhpur Non-Med Project Scientist Job Opening For Biotech, Biochem & Microbiology
ALL INDIA INSTITUTE OF MEDICAL SCIENCES JODHPUR
Basni Phase-II, Jodhpur-342005 (Raj)
Website: http://www.aiimsjodhpur.edu.in
File No.: AIIMS/REC/2024/115
Dated:-19-06-2024
Subject:...
Piramal BSc & MSc Microbiology Executive Job Opening – Appy Now
Piramal Microbiology Executive Job Opening - Apply Now
Senior Executive-Microbiology
Ahmedabad, Gujarat, India
JOB DESCRIPTION
Microbial analysis of water.
Microbial testing of samples.
Environmental Monitoring.
Maintenance of...
Piramal Apprentice Role For MSc Microbiology – Apply Online
Piramal Apprentice MSc Microbiology - Apply Online
Apprentice
Ahmedabad, Gujarat, India
JOB DESCRIPTION
Microbial analysis of water.
Microbial testing of samples.
Environmental Monitoring.
Maintenance of microbial cultures.
...
CIAB Fellowships For Microbiology, Biotech & Life Sciences – Attend Walk-In-Interview
CIAB Fellowships For Microbiology, Biotech & Life Sciences - Attend Walk-In-Interview
CIAB Fellowships For Microbiology, Biotech & Life Sciences - Attend Walk-In-Interview. Interested and eligible...
Hindustan Coca-Cola Beverages QA Executive Job For MSc Microbiology – Apply Online
HCCB MSc Microbiology QA Executive Job - Apply Online Now
Executive - Quality Assurance (19908)
Supply Chain
Wada Plant (11650200)
Job Description
To ensure all the products manufactured and...
Pfizer Microbiology Job Opening – Apply Online For Associate Role
Pfizer Microbiology Job Opening - Apply Online For Associate Role
Associate-Microbiology
Locations: India - Vizag
Time type: Full time
Posted on: Posted Today
Job Requisition...
Cytiva Microbiology Scientist Job – Life Sciences Apply Online
Cytiva Microbiology Scientist Job - Life Sciences Apply Online
Scientist I
Cytiva Karnataka,
Karnataka, India
Category: Science
Job Id: R1268029
Location: Karnataka, India
At Cytiva you...
Pfizer Microbiology Associate Job – Candidates With 1 Year Exp Can Apply Online
Pfizer Microbiology Associate Vacancy - Candidates With 1 Year Exp Can Apply Online
Associate - Microbiology
Locations: India - Vizag
Time type: Full time
Posted on: Posted Today
Job...
Diageo Hiring! Regulatory Affairs Job Opening For Food Tech, Microbiology, Biotech & Biochem Apply...
Diageo Hiring! Regulatory Affairs Job Opening For Food Tech, Microbiology, Biotech & Biochem Apply Online
Assistant Manager - Regulatory Affairs
Locations: Bangalore, India
Time type: Full time
Posted...
ICAR-IARI Microbiology Online Interview For JRF Post – Applications Invited
ICAR-IARI Microbiology Online Interview For JRF Post - Applications Invited
Online Interview
Please refer to our upcoming advertisement in Employment News date 15th-21st June, 2024. Applications are...
NIAB PhD Research Job For Biotech, Microbiology, Life Sciences & Biochem – Apply Online
NIAB PhD Research Job For Biotech, Microbiology, Life Sciences & Biochem - Apply Online
National Institute of Animal Biotechnology
(An Autonomous Institute of Dept. of Biotechnology,...
Zydus Takeda Hiring: Quality Control Officer Job For Microbiology – Apply Now!
Zydus Takeda Hiring: Quality Control Officer Job For Microbiology - Apply Now!
Officer - Quality Control (Microbiology)
Mumbai, Maharashtra
Job Description
Job Title: Officer - Quality Control (Microbiology)
Location:...
Avantor R&D Officer Job For MSc Biotech, Microbiology & Life Sciences – Apply Now
Avantor MSc Biotech Job - R&D Officer Vacancy For MSc Microbiology & Life Sciences - Apply Now
This job position has been filled
Officer - R&D
Locations:...
DIAGEO Biotech Quality Manager Job – Food Tech, Biochem & Microbiology Apply Online
DIAGEO Biotech Quality Manager Job - Food Tech, Biochem & Microbiology Apply Online
Assistant Manager - Quality
Locations: Barwaha, India
Time type: Full time
Posted on: Posted Today
Job...